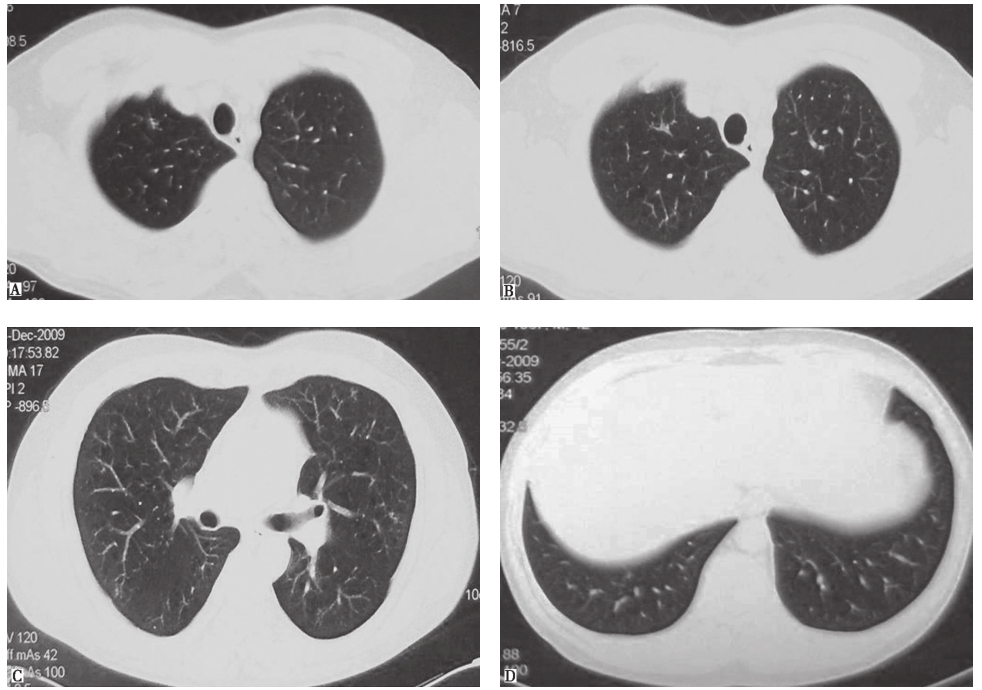

43岁男性,因咳嗽6个月入院治疗。期间自服抗生素、止咳化痰药物后无效。本病例是感染性疾病还是非感染性疾病?
一、入院疑诊
(一)病例信息
【病史】
男性患者,43岁,因咳嗽6个月入院治疗。患者于2009年3月无明显诱因出现咳嗽,间断有少量白痰,无咯血、胸痛,无发热、呼吸困难,自服抗生素、止咳化痰药物后无效,在当地省级医院就诊并住院治疗。期间查血常规、尿常规、肝肾功能,未见异常;肺功能提示为孤立性弥散功能下降;胸部CT可见双肺弥漫性结节影伴空洞样改变,不排除转移瘤诊断。患者来我院进一步诊疗。发病以来,患者食欲、睡眠尚可,二便正常,体重无明显变化。
患者既往身体健康,无高血压、糖尿病病史,否认传染病病史。职业为销售猪肉;吸烟1包/天×25年,已戒1个月;不嗜酒。家族史无特殊。
【体格检查】
生命体征平稳,SpO2 97%,浅表淋巴结未触及肿大,心、肺、腹未见异常,双下肢无水肿。
【肺功能检查】
当地医院查肺功能:FEV1/FVC 71.3%,FEV1 3.03L,FEV1 75.5%预计值,TLC 6.66L(92.6% 预计值),DLCO 51.6% 预计值。
【影像学检查】
胸部CT可见双肺多发小叶中心型小结节影,部分为空泡影,病灶以中上肺分布为主,肺底病变不明显,散在分布(图1)。


图1入院前3周胸部CT表现
(二)临床思辨
【临床特点】
1.患者为中年男性,隐匿起病。
2.主要表现为咳嗽,无明显喘息发作,无咯血、无发热,无体重下降。
3.患者既往长期大量吸烟。
4.胸部CT可见双肺沿支气管走行分布为主的多发结节及空洞,以中上肺分布为主,肺底和膈肋角肺野病灶稀少。
【思辨要点】
1.本病例是感染性疾病还是非感染性疾病?
多种感染性疾病可以引起肺内多发结节、空洞影:①血行播散性感染:如金黄色葡萄球菌感染、结核分枝杆菌感染、曲霉菌感染等,结节及空洞成像随机分布,且一般有明显发热中毒症状。本例患者双肺结节、空洞沿气道分布,且整个病程中都没有发热,与此类感染性疾病表现不符。②沿气道分布性感染:多为经过气道吸入所致感染,如结核分枝杆菌感染、非结核分枝杆菌感染、诺卡菌感染、曲霉菌感染等。虽然某些结核/非结核分枝杆菌感染可以没有发热等感染中毒症状,但经吸入感染结核分枝杆菌所致的肺内小结节,影像学表现常可见明显“树芽征”。但本病例无感染中毒征象,胸部影像学表现也无树芽征特点,患此类感染性疾病可能性不大。因此,对于本病例,应加强对肺非感染性疾病的鉴别。
2.对于本病例,有哪些肺部非感染性疾病需要鉴别?
一些非感染性疾病的胸部影像学表现也可见肺内多发结节、空洞影:①恶性肿瘤肺内转移,包括肺外肿瘤或原发肺肿瘤肺内转移,一般病灶的时相一致,转移结节在分布上呈现随机性,无明显中上肺部分布倾向;②职业肺病:多种金属粉尘暴露所致肺病的胸部影像学表现可见肺内随机分布或沿气道分布的结节,但一般没有空洞影。本例患者无类似暴露史,故不考虑职业肺病可能;③肺朗格汉斯细胞组织细胞增生症(pulmonary Langerhans cell histiocytosis,PLCH):以过量活化朗格汉斯细胞(Langerhans cell,LC)在器官内增殖、浸润为特征,病理特征为特异的组织细胞(朗格汉斯细胞)增殖,伴嗜酸细胞浸润。肺内病变可以为边界不清的结节影、空洞影、囊泡影。病变早期以小叶中心性结节为主,直径在1~5mm;病程后期表现为弥漫分布的囊泡影,囊泡壁厚薄及大小不一、形态不规则,囊泡直径通常为1cm,最大可至3cm;胸膜下肺大疱也不少见。病灶以双中上肺分布为著,自上而下发展,双侧肋膈角一般不受累。疾病晚期,病灶可以累及全肺。对于本病例,结合影像学表现,需要高度怀疑PLCH的可能。
综上所述,本病例为肺非感染疾病可能性大,其中PLCH可能性最大,可以行经皮肺穿活检、外科肺活检等以进一步明确诊断。
二、诊治过程
【辅助检查】
血常规、尿常规、便常规、肝肾功能、凝血功能未见明显异常;1,3-β-D葡聚糖试验(G试验)、半乳甘露聚糖试验(GM试验)、ESR、CRP未见明显异常;T淋巴细胞刺激γ-干扰素释放试验、腺苷脱氨酶、肺炎支原体IgM、军团菌抗体、肺炎衣原体、布氏杆菌抗体均阴性;肺癌标志物、癌抗原系列均阴性;抗核抗体谱、抗中性粒细胞胞质抗体均阴性。
诱导痰真菌涂片、痰涂片抗酸染色、弱抗酸染色及痰细菌培养、真菌培养、找瘤细胞(各2次)均阴性。
支气管镜检查:①镜下所见大致正常;②支气管肺泡灌洗液(BALF)细胞学分析:细胞总数6.7×106/L,吞噬细胞百分比89%,淋巴细胞百分比8%,中性粒细胞百分比3%;③BALF找瘤细胞阴性;④BALF送检真菌涂片、抗酸染色、弱抗酸染色、细菌培养、真菌培养及结核/非结核分枝杆菌-PCR均阴性。
经皮肺穿刺活检:镜下表现及免疫组化(CD1a染色)符合PLCH表现(图2)。
头颅鞍区MRI未见异常;肋骨、颅骨、骨盆等部位X线平片未见异常;骨髓穿刺及活检未见异常;心脏彩超未见异常。


图2经皮肺穿刺活检病理表现
活检肺组织中,小气道周边见一实变结节(A.HE染色,100×);朗格汉斯细胞及散在嗜酸细胞,前者细胞核不规则,扭曲,可见核沟(B.HE染色,400×);免疫组化CD1a阳性(C.CD1a染色,400×)
三、临床确诊
(一)临床信息
本例患者为中年男性,主要临床表现为慢性咳嗽,无发热、体重下降等,既往有长期大量吸烟史,胸部CT提示以上中肺部为主,沿气道分布的多发结节、空洞影,经皮肺穿活检明确为朗格汉斯细胞组织细胞增生症,系列影像学评估和骨髓穿刺等检查未见明确肺外组织受累,故而确诊为PLCH。
最后诊断:肺朗格汉斯细胞组织细胞增生症。
鉴于患者临床症状不重,无肺外系统受累,建议患者严格戒烟(包括被动吸烟)。患者在严格戒烟1个月后,症状逐渐减轻;3个月后复查胸部CT见双肺结节及空洞明显减少(图3);严格戒烟6个月后复查胸部CT显示双肺散在微小结节进一步减轻、减少(图4)。
图3严格戒烟3个月后复查胸部CT表现

图4严格戒烟6个月后复查胸部CT表现
(二)临床思辨
肺朗格汉斯细胞组织细胞增生症(PLCH)是一种罕见病,以20~40岁男性多见,90%~100%的PLCH患者有吸烟史。朗格汉斯细胞组织细胞增生症分为单器官受累、多器官受累及多系统受累,PLCH主要累及肺,部分病例也可合并骨骼、淋巴结等其他脏器受累。在肺内,主要累及细支气管和远端呼吸性细支气管。临床表现因病程不同而异,10%~25%患者无呼吸道症状,常因查体行影像学检查发现异常而进一步就诊。干咳、活动后气短是最常见的临床表现。10%~20%患者以自发性气胸起病,其中约半数患者可以反复发生气胸。另外,少数患者可以有胸痛,咯血不多见。患者一般无阳性体征,如杵状指和肺内湿啰音并不多见。
PLCH血清学检查无特异性指标,部分患者可以有低滴度自身抗体增高,部分患者可出现中性粒细胞比例轻度升高、血沉快,大多数患者血清学检查结果正常。PLCH患者中,10%~15%的人肺功能正常,70%~90%的人可以有不同程度弥散功能下降,肺功能常表现为低TLC、高残气量/肺总量(RV/TLC)和低DLCO。
PLCH患者HRCT可见特征性表现:病灶多分布于双肺中上,双侧肋膈角一般不受累,以多发边界不清的结节影、空洞影、囊泡影多见;病变早期以小叶中心性结节为主,直径为1~5mm;病程后期表现为弥漫分布的囊泡影,囊泡壁厚薄及大小不一、形态不规则,胸膜下肺大疱也不少见;晚期,病灶可以累及全肺。支气管镜检查(包括支气管肺泡灌洗、经支气管肺活检)有助于该病的诊断和鉴别诊断。
BALF细胞分类中CD1a阳性细胞比例>5%提示为PLCH。TBLB诊断阳性率在10%~40%,但发生气胸风险大,因此对于CT表现为弥漫分布的囊泡影或有多发胸膜下肺大疱患者不推荐行TBLB。外科手术肺活检能明确诊断,镜下表现为以细支气管为中心的星状间质性结节,病变时相不均一,结节、囊泡和纤维瘢痕可同时存在。免疫组化可见CD1a、S-100阳性朗格汉斯细胞。
严格戒烟是本病治疗的基础,75%患者在戒烟6~24个月后病情稳定或好转。对于症状严重或HRCT、肺功能提示病情严重者,可以加用糖皮质激素治疗[泼尼松0.5~1mg/(kg·d)],6~12个月内逐渐减量至停用(但此法疗效不确切)。对于终末期或合并严重肺动脉高压患者,可以考虑肺移植,但移植肺后还可能再发PLCH。
精要回顾与启示
临床上,遇到有长期吸烟史的中青年男性出现肺部多发结节、空洞影像,无明显感染中毒症状、消耗症状,肺部阴影分布以中上肺为主,下肺病变相对少时,首先需要警惕PLCH可能性。此类病变一般可以通过经皮肺穿活检、结合CD1a特殊染色等来明确诊断,而避免外科手术肺活检。在以结节性病灶为主的早期阶段,部分患者通过严格戒烟可缓解症状,从而改善预后,避免发展为肺内多发囊泡影、肺功能明显受损。对于该病,早期发现非常重要。
诊断流程
对于临床怀疑PLCH的患者,可以参考图5进行诊断和鉴别诊断。

图5PLCH诊断流程
免责声明
内容来源于人卫知识数字服务体系、人卫inside知识库,其观点不反映优医迈或默沙东观点。 此服务由优医迈与胤迈医药科技(上海)有限公司授权共同提供。
如需转载,请前往用户反馈页面提交说明:https://www.uemeds.cn/personal/feedback
人卫知识数字服务体系





 Copyright © 2025 Merck & Co., Inc., Rahway, NJ, USA and its affiliates. All rights reserved.
Copyright © 2025 Merck & Co., Inc., Rahway, NJ, USA and its affiliates. All rights reserved.
